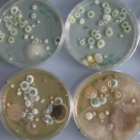
Bioaerosole - Mikrobielle Luftverunreinigungen

Ausbreitungsrechnung

Mit Hilfe der Ausbreitungsrechnung können flächendeckende Informationen zu Luftschadstoffbelastungen bereitgestellt werden. Neben der Ermittlung aktueller Belastungen ist es auch möglich, die Auswirkungen von Luftreinhaltemaßnahmen abzuschätzen und Prognosen für zu erwartende Belastungen zu berechnen.
Ausbreitungsrechnung nach TA Luft
Ein zentraler Baustein eines Genehmigungsverfahrens ist die Immissionsprognose, mit der die Immissionszusatzbelastungen einer geplanten Anlage ermittelt werden. Die wesentlichen Vorgaben einer solchen Ausbreitungsrechnung sind in der Technischen Anleitung zur Reinhaltung der Luft (TA Luft) beschrieben.
Ausbreitungsrechnung für Luftreinhaltepläne
Mit Hilfe großräumiger Ausbreitungsrechnungen ist es möglich, die Verursacheranteile einzelner Emittentengruppen an den Immissionsbelastungen zu analysieren. Solche Analysen sind ein wichtiger Baustein der hessischen Luftreinhalteplanung.
Geruch
Geruchimmissionen gehören aufgrund ihrer belästigenden Wirkungen zu den schädlichen Umwelteinwirkungen. Der Schutz vor Geruchsimmissionen wird im Gegensatz zu den klassischen Luftschadstoffen nicht durch massenbezogene Grenzwerte, sondern durch maximal zulässige Häufigkeiten von Geruchseinwirkungen geregelt.
Windrosen
Mit Hilfe von Windrosen kann die Häufigkeit von Windrichtungesverteilungen an einem Ort grafisch dargestellt werden. Die dafür erforderlichen Daten werden entweder gemessen oder berechnet. Das HLNUG hat flächendeckend für ganz Hessen mit einem Raster von 500 m x 500 m Windrosen berechnen lassen.
Ableitbedingungen für Abgase
Neben der Minimierung von Restemissionen ist auch die Festlegung von Mindestableithöhen ein wesentliches Element eines vorsorgenden Immissionsschutzes. Eine grundlegende Forderung ist ein ungestörter Abtransport der Abgase mit der freien Luftströmung sowie eine ausreichende Verdünnung der Abgase.
Bioaerosole - Mikrobielle Luftverunreinigungen
Durch anthropogene Tätigkeiten können die natürlichen Bioaerosolkonzentrationen deutlich erhöht werden. Daher gehören auch Bioaerosole zu den schädlichen Umwelteinwirkungen. Typische Bioaerosolemittenten sind Abfall- und Abwasserbehandlungsanlagen, Tierhaltungsanlagen und Verdunstungskühlanlagen.
Glossar Ausbreitungsrechnung
Im Arbeitsbereich der Ausbreitungsrechnung werden eine Vielzahl von Fachbegriffen verwendet. Das vorliegende Glossar Ausbreitungsrechnung stellt ein Verzeichnis aller gebräuchlicher Fachbegriffe zum Thema Ausbreitungsrechnung mit den dazugehörigen Definitionen dar.